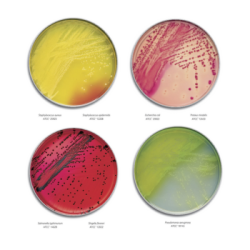
main product photo

BD® BBL™ Prepared Media Stacker™ Plates
Manufacturer: VWR International
Description
Prepared plated media are designed for the isolation of microorganisms from samples or specimens and come in 100 x 10 mm or 100 x 15 mm petri-style configurations unless otherwise noted. Plates contain a single medium, and feature an interlocking, stackable design to minimize sliding or sample disruption.
Features:
- Come in 100 x 10 mm or 100 x 15 mm petri-style configurations
- Plates are ready for immediate use
- Store at 2 to 8°C (36 to 46°F)
MacConkey II Agar MacConkey II Agar, a specially-designed improvement to MacConkey Agar, features increased inhibition of swarming Proteus spp., growth of enteric organisms and more definitive differentiation of lactose fermenters and nonfermenters.
Mannitol Salt Agar, with 7.5% sodium chloride in phenol red mannitol agar, is an efficient medium for the selective isolation of coagulase-positive staphylococci. Staphylococcus aureus colonies produce a golden color due to mannitol fermentation; most nonfermenting Staphylococcus colonies appear red.
Pseudosel Agar is the BD BBL™ medium of choice for the selective isolation and identification of Pseudomonas aeruginosa. It is a modification of King’s Tech Agar, stimulating enhanced pyocyanin production by Pseudomonas while inhibiting other organisms with cetrimide. Pseudosel Agar also detects the fluorescin produced by some pseudomonads.
XLD (Xylose-Lysine-Desoxycholate) Agar has been found to be highly efficient for the primary isolation of Shigella and Salmonella. It is a selective, differential medium, inhibitory to gram-positive organisms. Xylose fermentation, lysine decarboxylation and H2S production differentiate Salmonella spp. from the Shigella spp.
| SKU | Supplier # |
|---|---|
| 90006-206 | 221270 |
| 90006-208 | 221271 |
| 90005-044 | 297882 |
| 90006-218 | 221284 |

|
BD BBL™ Prepared Plated Media Brochure | Download |
Starting at $82.13
Select a product below and add it to your cart to request a quote.